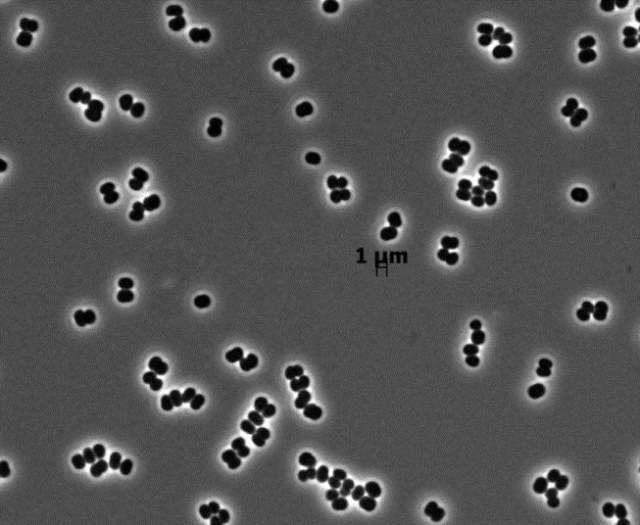
Новые виды флоры и фауны, открытые в 2014 году (10 фото) Новые виды флоры и фауны, открытые в 2014 году (10 фото)

Новые виды флоры и фауны, открытые в 2014 году (10 фото)
Международный Институт Исследования Видов выбрал 10 из 18 000 видов животных и растений, открытых в прошлом году. Как можно увидеть по списку, жизнь на Земле очень разнообразна. Коллекция включает в себя драконоводерево, креветку-скелет, геккона и микроба, который предпочитает стерильные комнаты, в которых собирают космические корабли.
Ученым предстоит еще открыть очень много новых видов животных и растений. Специалисты подсчитали, что существует около 10 миллионов видов, которые еще нужно назвать и классифицировать, и это в пять раз больше того, что нам уже известно. Однако стоит поторопиться, так как, хотя мы открываем около 15 000 новых видов, ежегодно мы теряем до 100 000 видов из-за вымирания.
1. Мушка-фея (Tinkerbella nana)
Эта крошка-оса отличается миниатюрными размерами и бахромчатыми крыльями, относясь к паразитарным насекомым семейства мимарид (Mymaridae). Ее размер всего 250 микрометров, и это одни из самых маленьких насекомых. Новый вид был открыт при уборке растений во вторичном лесу в Коста-Рике.
2. Креветка-скелет (Liropus minusculus)

Креветка-скелет была обнаружена в пещере острова Санта-Каталина у побережья Калифорнии. У нового вида необычный прозрачный вид, напоминающий костную структуру. Размер самцов достигает 3,3 мм, а самки около 2,1 мм.
3. Улитка с прозрачным панцирем (Zospeum tholussum)

Эта улитка была найдена в полной темноте на глубине примерно 980 метров под поверхностью пещер Лукина яма в западной Хорватии. У этой наземной улитки нет глаз, так как они не нужны ей в полной темноте. Также у нее отсутствует пигментация панциря, придавая ей внешний вид "призрака".
4. Листохвостый геккон (Saltuarius eximius)

Листохвостый геккон был обнаружен в каменистой местности в отдалённых влажных лесах Кейп-Мелвилла в северо-восточной части Австралии. Пятнистого геккона не так просто обнаружить, так как он отличается отличными способностями маскировки.
5. Олингито (Bassaricyon neblina)

Олингито – это скрытный хищник, который любит жить на деревьях во влажных тропических лесах Анд. Это первые хищное млекопитающее, обнаруженное в западном полушарии за последние 35 лет. Однако ему грозит исчезновение из-за вырубки лесов.
6. Драконово дерево Кавесака (Dracaena kaweesakii)

Высота этого дерева составляет 12 метров. Оно отличается мягкими листьями в форме мечей с белыми краями, а также кремовыми цветами и ярко-оранжевыми нитями. Драконовы деревья произрастают в области известняковых гор в Таиланде. Сейчас осталось 2500 драконовых деревьев.
7. Актиния ANDRILL (Edwardsiella andrillae)

Эта актиния была найдена во льду под шельфовым ледником Росса в Антарктиде. Это первый вид актиний или морских анемонов, живущих подо льдом. Он был открыт Антарктической геологической программой бурения ANDRILL. Это существо размером около 2,5 см зарывает свое бледно-желтое тело в ледниковый шельф, а сотни их щупалец остаются в холодной воде.
8. Микроб стерильных комнат (Tersicoccus phoenicis)

Микробы вида Tersicoccus phoenicis были обнаружены в стерильных помещениях, где собирают космические аппараты, и они потенциально могут загрязнить другие планеты, попав туда вместе с аппаратом. Эти микробы были собраны на полу двух отдельных стерильных комнат, расположенных на расстоянии 4000 км друг от друга во Флориде и во Французской Гвиане.
9. Амебоидный протист (Spiculosiphon oceana)

Амебоидный протист – это одноклеточный организм, размером 4-5 см, что делает его гигантом в мире одноклеточных. Этот вид был обнаружен в подводных пещерах в 50 км от юго-восточного побережья Испании. Интересно, что в этих же пещерах обнаружили плотоядных губок. На фотографии показана область головы в виде шара с лучеобразными пучками.
10. Оранжевый пеницилл (Penicillium vanoranjei)

Оранжевый пеницилл – род плесневелых грибов, который отличается ярко-оранжевым цветом. Он был назван в честь Принца Оранского из нидерландской королевской семьи. Гриб был найден в почве Туниса. Этот вид также производит дополнительную клеточную структуру в виде листов, которые защищают его от засухи.
Ученым предстоит еще открыть очень много новых видов животных и растений. Специалисты подсчитали, что существует около 10 миллионов видов, которые еще нужно назвать и классифицировать, и это в пять раз больше того, что нам уже известно. Однако стоит поторопиться, так как, хотя мы открываем около 15 000 новых видов, ежегодно мы теряем до 100 000 видов из-за вымирания.
1. Мушка-фея (Tinkerbella nana)

Эта крошка-оса отличается миниатюрными размерами и бахромчатыми крыльями, относясь к паразитарным насекомым семейства мимарид (Mymaridae). Ее размер всего 250 микрометров, и это одни из самых маленьких насекомых. Новый вид был открыт при уборке растений во вторичном лесу в Коста-Рике.
2. Креветка-скелет (Liropus minusculus)

Креветка-скелет была обнаружена в пещере острова Санта-Каталина у побережья Калифорнии. У нового вида необычный прозрачный вид, напоминающий костную структуру. Размер самцов достигает 3,3 мм, а самки около 2,1 мм.
3. Улитка с прозрачным панцирем (Zospeum tholussum)

Эта улитка была найдена в полной темноте на глубине примерно 980 метров под поверхностью пещер Лукина яма в западной Хорватии. У этой наземной улитки нет глаз, так как они не нужны ей в полной темноте. Также у нее отсутствует пигментация панциря, придавая ей внешний вид "призрака".
4. Листохвостый геккон (Saltuarius eximius)

Листохвостый геккон был обнаружен в каменистой местности в отдалённых влажных лесах Кейп-Мелвилла в северо-восточной части Австралии. Пятнистого геккона не так просто обнаружить, так как он отличается отличными способностями маскировки.
5. Олингито (Bassaricyon neblina)

Олингито – это скрытный хищник, который любит жить на деревьях во влажных тропических лесах Анд. Это первые хищное млекопитающее, обнаруженное в западном полушарии за последние 35 лет. Однако ему грозит исчезновение из-за вырубки лесов.
6. Драконово дерево Кавесака (Dracaena kaweesakii)

Высота этого дерева составляет 12 метров. Оно отличается мягкими листьями в форме мечей с белыми краями, а также кремовыми цветами и ярко-оранжевыми нитями. Драконовы деревья произрастают в области известняковых гор в Таиланде. Сейчас осталось 2500 драконовых деревьев.
7. Актиния ANDRILL (Edwardsiella andrillae)

Эта актиния была найдена во льду под шельфовым ледником Росса в Антарктиде. Это первый вид актиний или морских анемонов, живущих подо льдом. Он был открыт Антарктической геологической программой бурения ANDRILL. Это существо размером около 2,5 см зарывает свое бледно-желтое тело в ледниковый шельф, а сотни их щупалец остаются в холодной воде.
8. Микроб стерильных комнат (Tersicoccus phoenicis)
Микробы вида Tersicoccus phoenicis были обнаружены в стерильных помещениях, где собирают космические аппараты, и они потенциально могут загрязнить другие планеты, попав туда вместе с аппаратом. Эти микробы были собраны на полу двух отдельных стерильных комнат, расположенных на расстоянии 4000 км друг от друга во Флориде и во Французской Гвиане.
9. Амебоидный протист (Spiculosiphon oceana)

Амебоидный протист – это одноклеточный организм, размером 4-5 см, что делает его гигантом в мире одноклеточных. Этот вид был обнаружен в подводных пещерах в 50 км от юго-восточного побережья Испании. Интересно, что в этих же пещерах обнаружили плотоядных губок. На фотографии показана область головы в виде шара с лучеобразными пучками.
10. Оранжевый пеницилл (Penicillium vanoranjei)

Оранжевый пеницилл – род плесневелых грибов, который отличается ярко-оранжевым цветом. Он был назван в честь Принца Оранского из нидерландской королевской семьи. Гриб был найден в почве Туниса. Этот вид также производит дополнительную клеточную структуру в виде листов, которые защищают его от засухи.


Комментариев 2
Посетители, находящиеся в группе Гости, не могут оставлять комментарии к данной публикации.